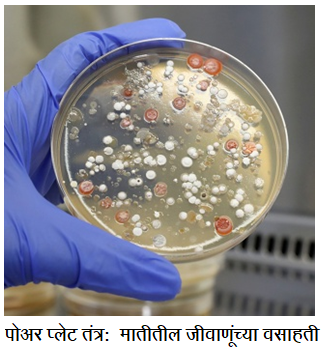

पर्यावरणातील जिवंत सूक्ष्मजीवांचे विशेषतः जीवाणू आणि बुरशी यांचे संकलन आणि मोजणी करताना सांख्यिकीय आणि गुणवत्तापूर्ण मोजमाप केले जाते. अत्यंत संवेदनशील अशा जैवतंत्रज्ञान उद्योगात अंतर्गत तसेच सभोवतालच्या परिसराची, विविध उंचीवरील सूक्ष्मजीवांची तपासणी करतात. प्रसंगी संकलनासाठी ड्रोन्सचाही वापर करतात. याशिवाय त्या पर्यावरणातील घन व द्रव नमुन्यांची तपासणी केली जाते. उदाहरणार्थ माती, पाणी, खाद्यपदार्थ, पेय, औद्योगिक कच्चा माल, इत्यादी.
मातीत वास्तव्य करणार्या जीवाणूंची संख्या मोजण्यासाठी प्रथम १ ग्रॅम मातीचा नमूना ९ मिलिलीटर निर्जंतुक सलाईनमध्ये घेतात. म्हणजे त्याची विरलता ०.१ ग्रॅम प्रति मिलिलीटर झाली. त्यातील १ मिलिलीटर नमुना ९ मिलिलीटर सलाईन मध्ये टाकून तो १० पटीने विरल करून घेतात. अशाप्रकारे त्याची क्रमाक्रमाने विरलता १००, १०००, १००००, आणि १००००० पट करून घेतात.
पोअर प्लेट तंत्र : प्रथम पाच पेट्रीप्लेट्समध्ये प्रत्येक विरलतेचा ०.१ मिलिलीटर नमुना निर्जंतुक पद्धतीने टाकून घेतात. नंतर १० मिलिलीटर द्रवरूप आणि निर्जंतुक घन पोषणमाध्यम त्या पाच पेट्रीप्लेट्स मध्ये ओततात. पेट्रीप्लेट्सना झाकण लावून त्या सपाट पृष्ठभागावर ३७ अंश सेल्सियस तापमानाला २४ तास ठेवतात.
स्प्रेड प्लेट तंत्र : यात पेट्रीप्लेट्समध्ये ओतलेले माध्यम घट्ट होऊ देतात. नंतर पाच पेट्रीप्लेट्समध्ये प्रत्येक विरलतेचा १ मिलिलीटर नमुना निर्जंतुक पद्धतीने टाकून घेतात. त्रिकोणी काचकांडीच्या सहाय्याने तो नमुना आगार पोषणमाध्यमावर पसरतात. या प्लेट्स ३७ अंश सेल्सियस तापमानाला २४ तास ठेवतात.
पोअर प्लेट तंत्रात ठेवलेल्या प्लेट्सपैकी, वसाहती स्वतंत्रपणे मोजता येतील अशी प्लेट निवडतात. पेट्रीप्लेटवर साधारण ३०० पर्यंत जीवाणूंच्या स्वतंत्र वसाहती मोजता येतात.
समजा, १:१०००० विरलतेचा ०.१ मिलिलीटर नमुना प्लेटवर घेतला आणि त्यावर ९८ वसाहती स्पष्ट मोजता आल्या. तर यावरुन आपण १ ग्रॅम मातीत किती जीवाणू (कॉलनी फॉर्मिंग युनिट्स) आहेत, हे सोबत दिलेल्या सूत्रानुसार मोजू शकतो.

याचा अर्थ घेतलेल्या एक ग्रॅम मातीत ९८,००,००० जीवाणूंचे वास्तव्य आहे.
स्प्रेड प्लेट तंत्रात हेच सूत्र वापरुन १ ग्रॅम मातीत वास्तव्य करणार्या जीवाणूंची संख्या मोजतात.
डॉ. रंजन गर्गे
